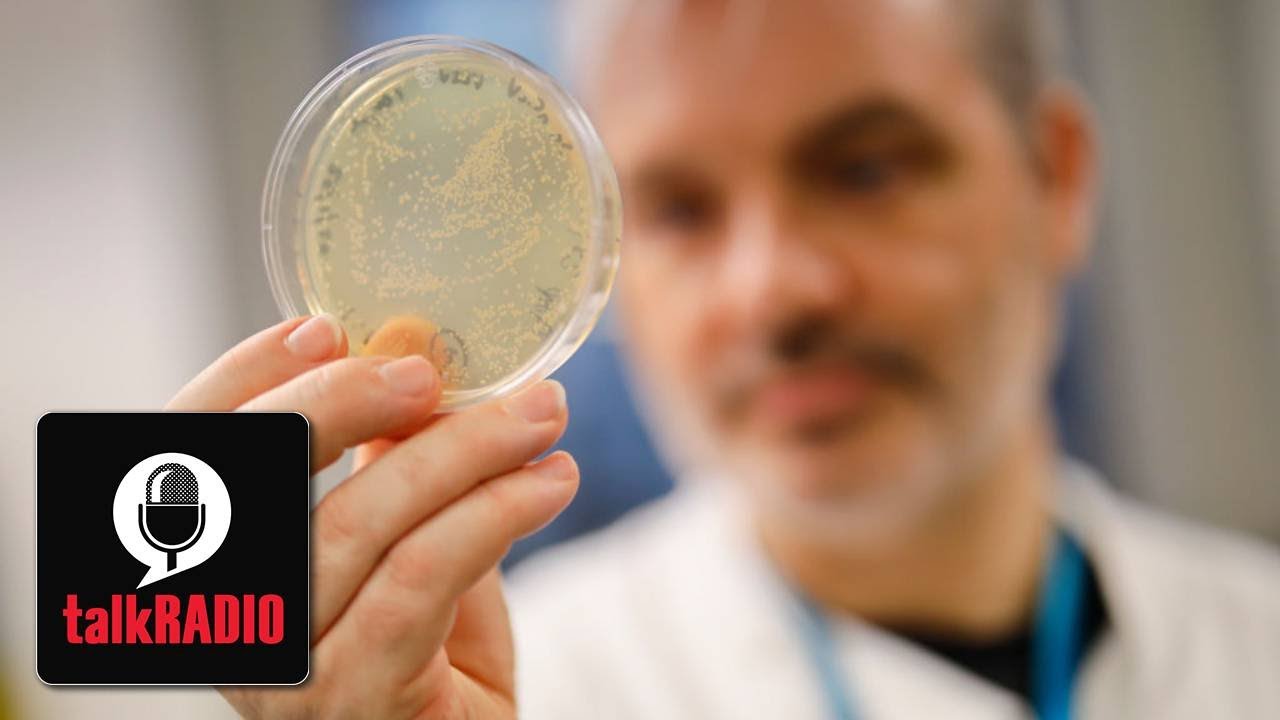

talkRADIO’s Ian Collins asks if a coronavirus vaccine is the only way to establish a return to normality and challenges those who are against inoculation.
“What is the fear of the coronavirus vaccine? Should we not be shouting bring on the vaccine – I mean a vaccine is just man’s natural evolutionary response to a clinical, viral scenario.”
It comes as some scientists say a vaccine could be ready for distribution by Christmas.